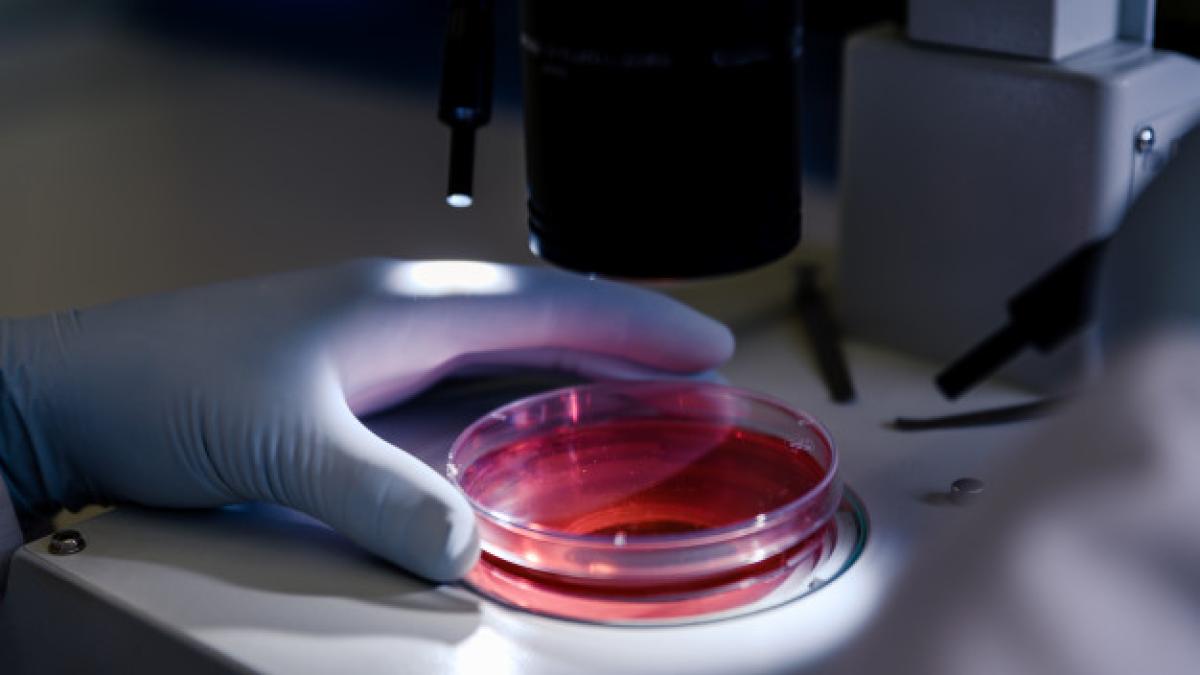
closeup-shot-person-studying-coronavirus-particles-with-microscope_181624-1142_86054600

În primăvara anului trecut, cu sprijinul Fondului de acțiune Toronto COVID-19, echipa sa a început să dezvolte o nouă metodă de măsurare a imunității la coronavirus la cei care s-au recuperat după boala COVID-19.
Acum echipa este gata să-și dezvăluie creația - un test care măsoară cu exactitate concentrația de anticorpi coronavirus în sânge care oferă rezultatul sub o oră.
Testul este unul ieftin respectiv o zecime din costul testelor de la ora actuală.
Studiul a fost publicat recent în revista Nature Communications.
Citește și: Vaccinul AstraZeneca. Anthony Fauci a găsit EXPLICAȚIA
„Testul nostru este la fel de sensibil, dacă nu chiar mai bun decât orice alt test disponibil în prezent în detectarea nivelurilor scăzute de anticorpi IgG, iar specificitatea acestuia, cunoscută și sub numele de rată fals pozitivă, este la fel de bună ca cel mai bun test de anticorpi de pe piață”, a spus Stagljar.
Testele serologice detectează anticorpi, molecule de proteine din sânge care recunosc și neutralizează Sars-CoV-2 pentru a preveni infecția. Astfel de teste sunt văzute ca un instrument cheie pentru experții în sănătate publică care doresc să măsoare imunitatea populației pentru a putea gestiona mai bine pandemia care se află plină desfășurare.